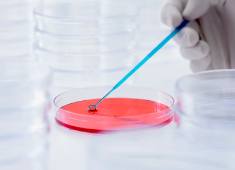
image.png

浙江常見幹細胞檢測機構有哪些,靠譜嗎
2024-11-12 12:03:23 來源: 小編 咨詢醫生
浙江作爲我國經濟發達地區,生物科技産業也取得了顯著的成果。在幹細胞研究領域,浙江擁有多家專業的幹細胞檢測機構。
以下是浙江常見的一些幹細胞檢測機構及其靠譜程度的分析。
1.浙江省幹細胞研究與轉化中心
浙江省幹細胞研究與轉化中心成立于2013年,是由浙江省人民政府、浙江大學、杭州市人民政府共同投資建設的省級科研平台。該中心擁有一流的科研設施和專業的技術團隊,緻力于幹細胞的基礎研究與臨床應用。在幹細胞檢測方面,該中心具備較高的權威性和可靠性。
2.浙江大學生物醫學工程與儀器科學學院
浙江大學生物醫學工程與儀器科學學院是我國生物醫學工程領域的重要研究基地。學院設有生物醫學工程實驗室,具備先進的幹細胞檢測設備和技術。在幹細胞檢測方面,該學院具有較高的專業性和可靠性。
3.杭州師範大學醫學院
杭州師範大學醫學院在生物醫學領域具有較高的研究水平,其幹細胞研究實驗室具備完善的幹細胞檢測設備和專業的技術團隊。在幹細胞檢測方面,該實驗室同樣具有較高的權威性。
4.甯波市幹細胞研究與轉化中心
甯波市幹細胞研究與轉化中心成立于2017年,是甯波市科技創新服務平台。該中心擁有一支高水平的研究團隊,具備先進的幹細胞檢測技術。在幹細胞檢測方面,該中心具有一定的權威性和可靠性。
關于靠譜程度,以上提到的幾家機構在幹細胞檢測方面都具備較高的權威性和專業性。
但是,靠譜程度還需要從以下幾個方面進行評估:
1.機構的資質認證:具備相關資質認證的機構,說明其檢測能力和服務質量已經得到了國家或行業的認可。
2.機構的科研實力:具備較強的科研實力和豐富的科研經驗,說明其在幹細胞檢測領域具有較高的技術水平。
3.機構的口碑評價:通過了解其他客戶的評價,可以了解該機構在服務過程中的态度、效率和質量。
總之,浙江地區的幹細胞檢測機構較多,靠譜程度各有不同。在選擇幹細胞檢測機構時,請務必了解其資質、科研實力和口碑評價,以确保檢測結果的準确性和可靠性。
-
上一頁: 捐血幹細胞全過程怎樣的,需要注意哪些事項
-
下一頁: 造血幹細胞捐獻是獻血嗎,二者有何區别
- 2024-10-11幹細胞與傳統治療有何區别?未來治療前景如何?
- 2024-10-24造血幹細胞移植過程中尿血是什麽原因?如何處理?
- 2024-11-01地貧患者幹細胞移植經驗:成功率與費用分析!
- 2024-10-25造血幹細胞移植的操作過程是怎樣的?
- 2024-11-12幹細胞移植對供者有什麽要求,有多嚴格
- 2024-10-28骨科疾病中幹細胞扮演什麽角色?
- 2024-10-11吳京分享幹細胞抗衰老失敗經曆?有何經驗教訓?
- 2024-09-02神經幹細胞移植成功率以及費用
- 2024-08-27幹細胞治療脫發價格,附治療過程和成功率
- 2024-09-04幹細胞療法肌腱再生有效果嗎,附原理和成功案例
- 2024-09-27貝拉醫療門診部(廣州)怎麽樣
- 2024-08-16幹細胞改善鼻炎效果如何,幹細胞改善鼻炎的原理
- 2024-08-02做幹細胞移植要多少錢,做幹細胞移植手術有風險嗎
- 2024-09-13幹細胞移植排異期多久,如何應對排異反應
- 2024-08-06間充質幹細胞治療,間充質幹細胞治療的原理
- 2024-09-13臍帶血造血幹細胞存儲有意義嗎,能治療哪些疾病
- 2024-09-27商洛的幹細胞存儲機構哪家可靠,選擇标準有哪些
- 2024-07-22幹細胞移植費用,幹細胞移植成功率高嗎
